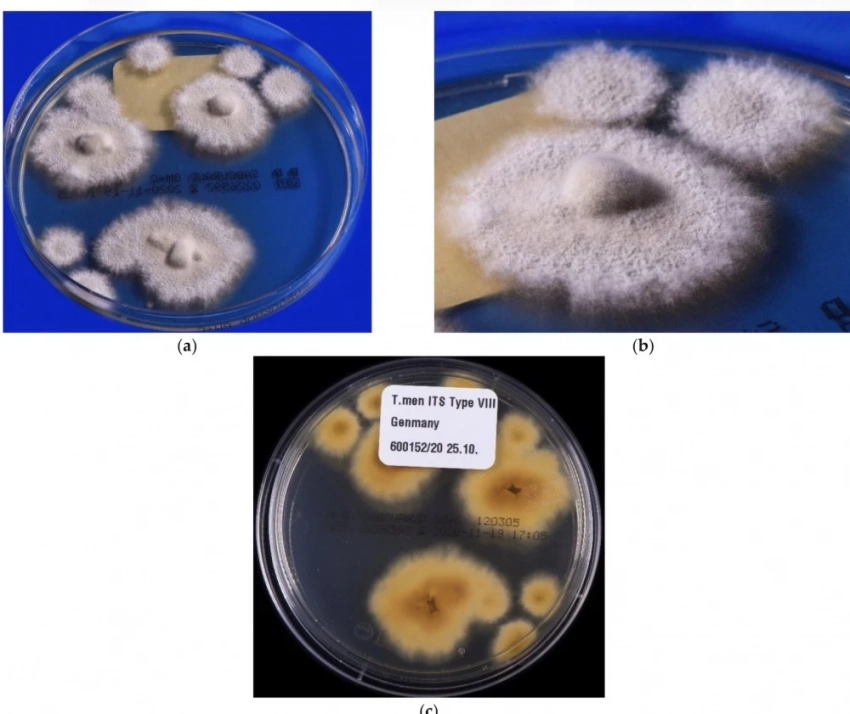
В Европе стремительно распространяется супергрибок, поражающий пах и ягодицы

Олимпиада PROD приглашает к участию старшеклассников со всех стран
Первая международная олимпиада по промышленной разработке PROD открывает свои двери для англоговорящих школьников 8-12 классов со всего мира. Промышленная разработка подразумевает создание программных решений и технологий, которые обычно разрабатываются большими командами в ведущих ИТ-компаниях. PROD предоставляет...